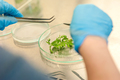
Dzień Otwarty KUL 2015.  Fot. Ewelina Lachowska

- Uniwersytet
- Wydziały
- Nauka
- Badania naukowe
- Publikacje
- Vademecum naukowca
- HR Excellence in Research
- Szkoła Doktorska
- Samorząd Doktorantów KUL
- Lubelski Festiwal Nauki
- Księgarnie Internetowe
- Opera Omnia Josepha Ratzingera
- Nasze sukcesy
- Projekty międzynarodowe
- Regionalna Inicjatywa Doskonałości
- Repozytorium Instytucjonalne KUL - ReKUL
- Platforma Czasopism KUL - CzasKUL
- Centrum Badań nad Dyplomacją KUL
- Sieć Uniwersytetów Trójmorza
- Studia
- Regulamin studiów
- Obiekty KUL
- Stypendia i sprawy socjalne
- Domy studenckie
- Sport KUL
- Języki obce
- Erasmus+
- MOST
- Praktyki
- Studium Wychowania Fizycznego i Sportu
- Akademia Artes Liberales
- Biuro Karier
- Studenci cudzoziemcy
- Studenci z niepełnosprawnością
- Zajęcia w języku angielskim
- Uczelniany Samorząd Studentów
- Życie akademickie
- Studia podyplomowe
- Szkoła Języka i Kultury Polskiej
- Jakość kształcenia
- Lubelska Szkoła Dyplomacji
- Centrum Polonijne KUL
- Centrum Studiów przy Areszcie Śledczym w Lublinie
- KULtowe Studia
- Dla kandydatów
- Absolwenci
- Biblioteka
- Duszpasterstwo
- KULtura

- Dla biznesu
- e-księgarnie
- projekty europejskie
- współpraca międzynarodowa
- przetargi
- linki
- e-kul
- kontakt
Katolicki Uniwersytet Lubelski Jana Pawła II